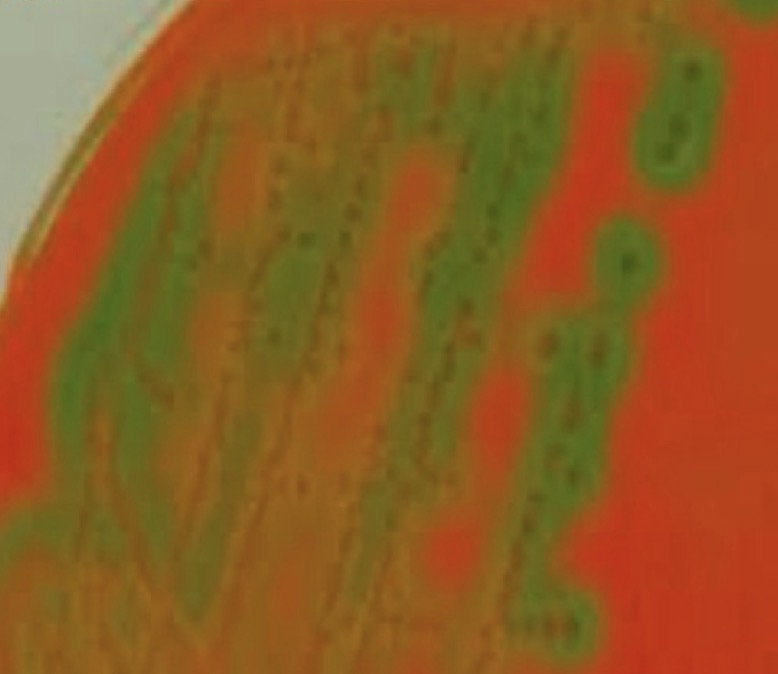
<p>A- identify</p><p>B- Identify this media</p><p>C- Morphological features seen</p><p>D- Give example</p><p>E- features under microscope</p><p>F- biochemical reaction</p>
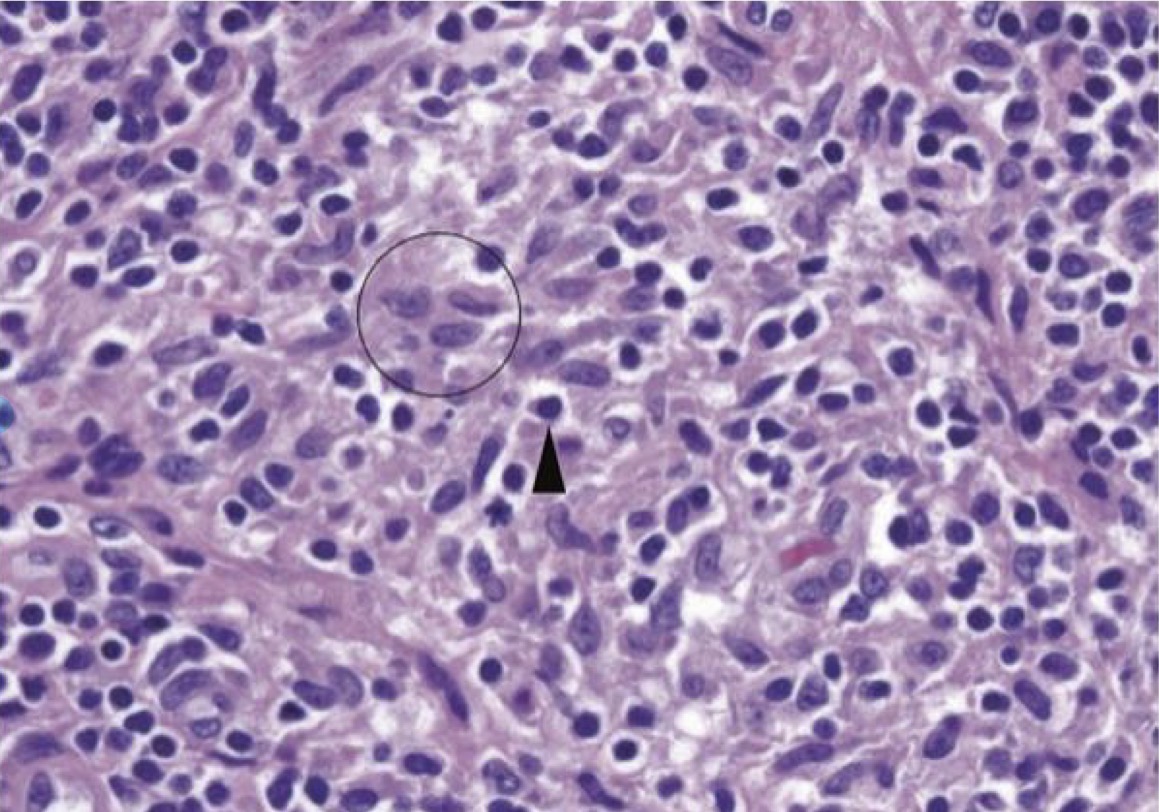
<p>A- identify</p><p>B- identify the circle with describe</p><p>C- identify the arrowhead with describe</p>
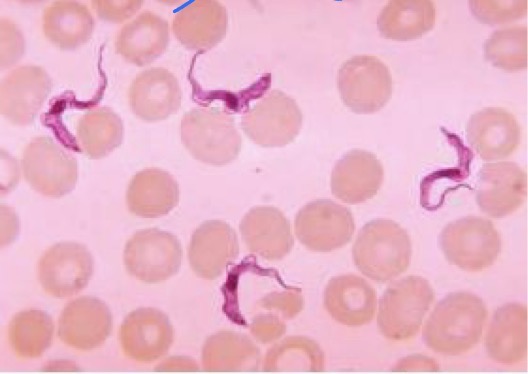
<p>A- what is the method of examination used here </p><p>B-identify the used technique</p><p>C- how to use it</p><p>D- what is the organism</p><p>E- <strong>what is the stain</strong></p><p></p>
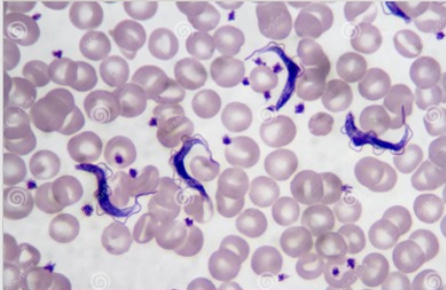
<p>A- what is the method of examination used here</p><p>B-identify the used technique</p><p>C- what is the type of this technique in this picture </p><p>D - how to use it</p><p>E- what its importance</p>

POD OSPE
1/108
There's no tags or description
Looks like no tags are added yet.
Name | Mastery | Learn | Test | Matching | Spaced | Call with Kai |
|---|
No analytics yet
Send a link to your students to track their progress
109 Terms

A- identify
B- Histological features
A-White fibrous CT
B- formed mainly of collagen fibers type 1 and few cells ( fibroblast that have flat nucleus + fibrocyte the have oval nucleus ) and few matrix
have two types :-
Regular : parallel collagens bundles with fibroblast and fibrocyte between the bundles
site : in cornea and tendon
Irregular : irregular collagen bundles with fibroblast and fibrocyte between the bundles
site : sclera of the eye , fibrous layer of periosteum, perichondrium and capsule of organ

A- identify
B- Histological features
C- Function
D- resemble to what cell ?
A-Mast cell
B-Cell shape: oval
Nucleus shape:oval
Cytoplasm: basophilc,filled with granules
Type of stain : metachromatically stained by
toluidine blue they are stained purple instead of blue.
C-Secret Histamine , heparin,serotonin
D- They resemble to the basophils ( WBC )

A- identify
B- Histological features
C- Function
A- plasma cell
B-Origin: B Lymphocyte
Cell shape: oval
Nucleus: oval eccentric contain chromatin with cart wheel appearance
Cytoplasm: basophilic due to excessive RER ,Have pale area called negative Golgi images Contain acidophilic
Russel bodies
C-Produce immunoglobulin

A- identify
B- Histological features
A- white collagen fibers
B-Origin : fibroblast
Bundle branch but Single fibers doesn’t branch
white color in fresh state , tough ( resist to stretch )
Each fiber consist of fibril that formed of type 1 tropocollagen molecules that formed from fibroblast

A- identify
B- Histological features
C- sites
A- Reticular fiber
B-Origin: from fibroblast, reticular cell
Fibers : reticular fiber
very thin fiber (single fiber branch and doesn’t form bundles) and anastomose to form a network
EM:
Composed of type III colagen coated by glycoprotein
Site :stroma of organ : Liver, spleen, lymph node

A- identify
B- Histological features
C- Sites
A- yellow elastic CT
B-cells : fibroblast
Fiber : elastic , Yellow in fresh state , elastic in nature fibers branched and may form elastic membrane
No bundle
EM: amorphous protein in the centre called Elastin coted by oxytalan
C- Site: vagina , arteries ,Trachea, Ligamentum flavum

A- identify
B- Histological features
C- Function
D- Sites
A- white adipose CT
B- Cell: oval, unilocular adipocyte
Nucleus: flat and peripheral
Cytoplasm:Thin rim , one large fat droplet ,(signet ring appearance)
Separated by loose Ct
Less blood capillaries
Type of stain : stains orange in Sudan III
EM: few mitochondria and SER around nucleus
C- Storage fat, support organs. Heat insulator
D- perinephric fat , subcutaneous tissue

A- identify
B- Histological features
C- Function
D- Sites
A- Brown adipocyte CT
B-Cell: rounded multilocular adipocyte
nucleus: central, rounded.
Cytoplasm: profuse , multiple fat small droplets
Separated by loose CT
more blood capillaries
EM : numerous mitochondria surrounding the fat droplets
C- Heat generation
D- mediastinum , between 2 scapula

A- identify
B- Describe
A- Serous inflammation, skin blister .
B- Epidermis separated from the dermis by serous fluid

A- identify
B- Describe A&B
A- Ulcer
B- (A) chronic duodenal ulcer ,(B) ulcer crater with an inflammatory exudate in the base

A- identify
B- Describe
A-Gastric Ulcer
B- (A) Large ulcer with several smaller ulcer surrounding by redness ,(B) ulcer cater with an inflammatory exudate in the base

A- identify
B- Describe A&B
A- coagulative necrosis
B- (A) wedge shaped Kidney infarct ( yellow ) ,(B) Edge of the infarct , with normal kidney and necrotic cell in the infarct , showing preserved cellular outlines with loss of nuclei and an inflammatory infiltrate

A- identify
B- Describe A&B
A- liquefactive necrosis of brain
B- (A) infarct in the brain showing dissolution of the tissue ,(B) liquefied tissue contains necrotic cell debris and macrophages

A- identify
B- Describe
A- Tuberculosis of lung
B- (A) large area of caseous necrosis contain yellow white cheesy debris ,(B) necrosis , at the upper right surrounded by granulomatous inflammatory cells

A- identify
B- Describe A&B
A- Fat necrosis
B- (A) white chalky appearance fat saponification ,(B) shadowy outlines of fat cells with basophilic calcium deposits

A- identify
B- what is its principal of this
C- Give example With its morphology
D- what is its principal techniques
E- Give another types of same principal techniques
F- other techniques for diagnosis of viral infection
A- electron microscope
B- used for showing structural details of viruses
C- Corona virus , club shaped , spikes project from the surface
D- Direct demonstration of the viral AG or nucleic acid
E- microscope ( LM , Fluorescent )
F- identification and isolation of virus , serological demonstration of AB into the virus

A- identify
B- what is its principal of this
C- what is its principal technique
D- Give another types of same principal technique
E- other techniques for diagnosis of viral infection
A- Double immunodiffusion
B- Soluble antigen with soluble antibody forming antigen- antibody complex that form insoluble visible precipitate
C- Direct demonstration of the viral AG or nucleic acid
D- microscope ( EM , LM fluorescent ) PCR
E- identification and isolation of virus , serological demonstration of AB into the virus

A- identify
B-Used for
C- How to prepare it
D- The morphology
E- Example
F- List other cytopathic effect
Types of tissue culture
A- Tissue culture
B-Cultivation of viruses
C- 1- tissue + trypsin to separate cells. 2- separate cells + growth media in flat sided bottles
D- cytopathic effects ( multinucleated giant cells )
E- Herpes simplex virus
F- Ballooning , Rounding
Types of tissue culture


A- identify this media
B- Give example
C- Give another type of transport media
A- Stuart media
B- gonococci , streptococci
C- Amies media , Cary Blair transport media

A- identify this media
B- use
C- Give another type of transport media
A- Amies media
B- Throat , vagina , wound
C- Cary Blair transport media , Stuart media

A- identify this media
B- use
C- Give another type of transport media
A- Cary Blair transport media
B- rectal swabs
C- Amies media, Stuart media

A- identify this stain
B- Give example
C- Give other examples of stains
A- Negative stain ( Indian ink )
B- sterptococci pneumonia
C- Gram stain , Acid fast stain , Fluorescent stain
A- identify
B- Identify this media
C- Morphological features seen
D- Give example
E- features under microscope
F- biochemical reaction
A- Blood agar
B- enriched medium
C- alpha hymolysis
D- streptococci pneumonia
E- Gram positive cocci in pairs
F- Coagulase -ve

A- identify this media
B- Give example
C- Morphological features seen
D- features under microscope
E- biochemical reaction
A- Blood agar
B- proteus spp
C- swarming due to high motility of organism in the cultural media , have fishy odour
D- Gram negative bacilli
E- Urease +ve

A- what is the name of the test
B- what is the principal of the test
C- Give example of +ve organism
D- Give example of -ve organism
A- Coagulase test
B- Fibrinogen —> ( by Coagulase in plasma ) into fibrin ( clot )
C- Staphylococcus aureus ( gram positive cocci in grapes like clusters ) ( beta homlysis )
D- staphylococcus epidermidis

1- Type A (Augmented and Predictable)
-Secondary Effect: Bad effect consequent to
normal therapeutic action of the drug
2-Type B (Bizarre and unpredictable)
- Allergy (Hypersensitivity) : Unpredictable
abnormal response to drugs mediated by the
immune system
3- TypeA (Augmented and Predictable)
-Supersensitivity (Intolerance) : Exaggerated( increase )
normal action in response to usual therapeutic
doses of the drug

Type B: Bizzare and unpredictable
Idiosyncrasy (Pharmacogenetics):
Unpredictable abnormal response due to a
pharmacogenetic basis.
2 Examples:
Succinylcholine apnea
Hemolytic anemia (G6PD) deficiency(Aspirin)

Type D(Delayed effects of the drugs).
• Teratogenicity: The ability of the drug to
induce fetal malformations and adverse
fetal outcomes
Example:
- Tetracyclines >>> Teeth & Bone abnormalities

A. Supportive treatment: ABCDs
B. Symptomatic treatment
C. Specific treatment:
1. Detection of the poison
2. Termination of exposure to the poison
3. Decontamination
4. Enhance elimination of the poison
5. Administration of a specific antidote
Antidote: Atropine & Pralidoxim

Type B: Bizzare and unpredictable
Idiosyncrasy (Pharmacogenetics):
Unpredictable abnormal response due to a
pharmacogenetic basis.
2 Examples:
Succinylcholine apnea
Malignant hyperthermia (Halothane)

A- identified A & B
B - What is the name of enzyme used here and its function
C - related to any molecular techniques ?
D- give another example from the same molecular techniques
A- (A) Staggered cut : produce to cohesive or sticky ends , (B) Blunt cut : a cut along axis of symmetry
B- restriction endonuclease enzymes isolated from bacteria that play a role in protecting the bacteria from virus , each restriction enzyme cleaves both strands of DNA at specific nucleotides
C - Cloning ( Amplification techniques )
D- PCR

A- identified the molecular techniques here
B - What is the pre requisites of it
C - identified 1-2-3-4
D- Give 4 application of this technique
A- PCR , a test tube method ( in Vitro) , amplifies a selected DNA fragments
B- DNA primers : 2 sets of primers ,20-30 nucleotides long ( good primer should be specific contains 40-60% GC )
Taq polymerase
dNTPs ( deoxynucleotides triphosphate )
C - 1- DNA , 2- Taq polymerase, 3- nucleotides , 4, primer
D- forensic analysis of DNA samples , Gene therapy for genetic diseases , synthesis of DNa in sufficient quantities for sequencing or cloning , synthesis of proteins like insulin or vaccine like hepatitis B or antibodies

A- identified the molecular techniques here
B - What is the pre requisites of it
C - identified its steps 1,2,3
D- give 4 applications of this technique
A- PCR , a test tube method ( in Vitro) , amplifies a selected DNA fragments
B- DNA primers : 2 sets of primers ,20-30 nucleotides long ( good primer should be specific contains 40-60% GC )
Taq polymerase
dNTPs ( deoxynucleotides triphosphate )
C -
1- Denaturation ( 1 minute 94C)
2- Annealing ( 45 seconds 54C)
3- extension ( 2 minutes 72 C ) only dNTP
, 2- Taq polymerase, 3- nucleotides , 4, primer
D- forensic analysis of DNA samples , Gene therapy for genetic diseases , synthesis of DNa in sufficient quantities for sequencing or cloning , synthesis of proteins like insulin or vaccine like hepatitis B or antibodies

A- identified the molecular techniques here
B - What is its principal
C- used for what
D- give other examples of same molecular technique
A- Western blotting ( separation and identification techniques)
B- Antibody - antigen interaction
( antigen is the protein of interest ) ( antibody is the probe )
C- used for detect specific proteins by hybridization with specific antibody probe
D- southern ( for DNA ) , northern ( for RNA )

A- identified the molecular techniques here
B - What is its steps
C- used for what
D- give other examples of same molecular technique
A- Southern blotting ( separation and identification techniques)
B- 1- Restriction fragment preparation 2- Electrophoresis 3- Blotting 4- Hypridization with radioactive probe 5- Rinsing of unattached probe 6- Autoradiography
C- used for detect specific DNA sequence by using labelled DNA probe
D- western ( for protein ) , northern ( for RNA )

1. Identify the shown lesion.
2. What is the serious complication of such a condition?
3. What is the most common origin of such a finding? extremities.
1. Saddle pulmonary embolus.
2. It can cause sudden death from acute cor pulmonale.
3. DVT of lower extremities.

1. Identify the condition.
2. Describe the morphology?
3. What is the possible life-threatening complication in such a condition?
1. Cerebral edema.
2. The sulci are narrowed while the gyri are swollen and flattened.
3. Brainstem herniation.

1. Identify A.
2. Describe B.
1- Large abdominal atherosclerotic aortic aneurysm proximal to the iliac bifurcation (sectioned longitudinally), filled with abundant layered thrombus.
2- These are "lines of Zahn" which are the alternating pale pink bands of platelets with fibrin and red bands of RBC's.

Given that under microscopic examination of the lesion in A, there was no evidence of inflammation or bacterial colonization:
1. Describe the shown lesion in A.
2. Identify the condition in A?
3. Identify the complication happened in B? What is the potential cause of such a finding in the context of A?
1- Small pink vegetations on the leftmost aortic cusp margin.
2- Nonbacterial thrombotic endocarditis (marantic endocarditis).
3- Splenic infarction, Portions of the vegetations in A have embolized to the spleen.

1. Identify the condition.
2. Describe the morphology?
3. Mention two possible clinical findings in such a case?
1- Pulmonary infarct.
2- Wedge-shaped hemorrhagic (red) infarct based on the pleura.
3- Chest pain and hemoptysis.

You’re given with a kidney specimen:
1. Describe the gross lesion.
2. Describe the microscopic morphology?
3. What is the usual cause of such a condition?
1- Wedge-shaped pale area of coagulative necrosis (infarction) in the cortex.
2- The cells at the left appear pale and ghost-like (necrosis) compared to the normal renal parenchyma at the far right.
3- Thromboemboli usually originate from a thrombus in the heart or aorta.

1. Describe the gross morphology in A?
2. Describe the microscopic morphology in B?
3. Identify the condition.
1- It shows nutmeg liver (red central areas surrounded by tan viable parenchyma).
2-It shows centrilobular hepatic necrosis with hemorrhage and scattered inflammatory cells.
3- Liver with chronic passive congestion and hemorrhagic necrosis.

A- identity
B- Describe
A- Benign prostatic hyperplasia
B - The prostate is enlarged. Cut surface shows variable
sized nodules bulging from the surface. Urethra is
compressed

A- identity
B- Describe
A- Benign prostatic hyperplasia under microscope
B-( Glandular proliferation, the form of
(Glandular prolferation) in the form of
aggregation of(small to larg cystically glands )
(Stroma is also proliferating)

A- Identify
B- Describe
A- squamous metaplasia
B-Section from urinary bladder showing
squamous metaplasia of Urothelium as a
result of shistosoma hematobium
urothelial or transitional
epithelium is changed to keratinized
stratified squamous

A- identify
B- Describe
A- Squamous metaplasia
B- Section of endocervix showing
opening of endocervical gland
(formed of columnar epithelium)
through metaplastic squamous
epithelium.
Inflammatory cells
infiltrate epithelium and stroma.

A- identify
B- describe
A- Columnar Metaplasia
B- This endoscopic view demonstrates Barrett
esophagus; areas of mucosal erythema of the
lower esophagus, with islands of normal pale esophageal squamous mucosa.

A- identify
B- describe
A- Columnar Metaplasia
B- Columnar metaplasia of esophageal squamous
epithelium as a result of GERD (Barret’s
esophagus) >> Stratified squamous changed to
columnar mucus secreting with goblet cells

A- identify
B- describe
A- Progression from hyperplasia to invasive carcinoma
B-
(A) Goblet cell hyperplasia
(B) basal cell hyperplasia
(C) squamous metaplasia
(D) squamous dysplasia
(E) carcinoma-in-situ (CIS)
(F) invasive squamous carcinoma

A- Identify
B- Describe
A- Cytologic features of CIN in papanicolaou smear
B- Superficial squamous cells may stain either red or blue.
• A, Normal exfoliated superficial squamous epithelial cells with small nucleus and abundant cytoplasm.
• B, CIN 1—low-grade squamous intraepithelial lesion (LSIL).
• C and D, CIN II and CIN III, respectively—both high-grade squamous
• the increase in the nucleus-to-cytoplasm ratio and abnormal nuclear morphology as the grade of the lesion increases

A- identify
B- describe
C- originate from ?
A- Squamous Papilloma
B- papillary mass protruding from palat
C- from benign epithelial tissue

A- identify
B- describe
C- originate from ?
A- squamous papilloma
B- tumor consist of fibrovascular core lined by stratified squamous epithelium
C- from benign epithelial tissue

A- identify
B- describe
C- originate from ?
A- Colonic adenoma
B- Tubular colonic adenoma consisting mostly of round or oval glands
C- from benign epithelial tissue

A- identify
B- describe
C- originate from ?
A- Colonic adenoma
B- (A) Sessile(dome shaped) colonic polyp (B) Pedunculated(stalked) colonic polyp
C- from benign epithelial tissue

A- identify
B- describe
C- originate from ?
A- Urothelial papilloma
B- Papillary fronds with fibrovascular cores are lined by normal appearing urothelium
C- from benign epithelial tissue

A- identify
B- describe
C- originate from ?
A- Urothelial papilloma
B- Papillary fronds with fibrovascular cores are lined by normal appearing urothelium
C- from benign epithelial tissue

A- identify
B- describe
C- originate from ?
A - squamous cell carcinoma
B- Well differentiated squamous cell carcinoma formed of nests of malignant squamous epithelial cells with keratin pearls
C- from malignant epithelial tissue

A- identify
B- describe
C- originate from ?
A - squamous cell carcinoma
B- Invasive SCC present as ulcerating nodule. The ulcer have irregular borders and dirty necrotic floor.
C- from malignant epithelial tissue

A- identify
B- describe
C- originate from ?
A- Colonic adenocarcinoma
B- Opened colectomy specimen showing exophytic cauliflower mass
C- from malignant epithelial tissue

A- identify
B- describe
C- originate from ?
A- Colonic adenocarcinoma
B- The cancerous glands are irregular in shape and do not resemble the normal colonic glands. Their lining shows nuclear enlargement and hyperchromasia
C- from malignant epithelial tissue

A- identify
B- describe
C- originate from ?
A- Fibroadenoma of the breast
B- The tumor formed of benign looking glandular and Stromal elements.
The border is sharply delimited from the surrounding tissue
C- from benign epithelial tissue

A- identify
B- describe
C- originate from ?
A- Fibroadenoma of the breast
B- rubbery, white, well-circumscribed, capsulated small mass that have a homogenous slightly gelatinous cut surface
C- from benign epithelial tissue

A- identify
B- describe
C- identify the marked structure
A- chronic inflammation
B- inflammatory infiltrate of chronic inflammation mainly consist of Mononuclear cells (also known as "round cells"). 1. Lymphocytes, 2. Plasma cells, 3. Macrophages.
C- plasma cells
A- identify
B- identify the circle with describe
C- identify the arrowhead with describe
A- Chronic inflammation ( histocyte and lymphocyte in inflammatory tissue )
B- ( circle ) Histocyte , Pale folded nuclei surrounded by light pink cytoplasm ,The cell borders are indistinct , pale chromatin
C- ( arrowhead ) Lymphocyte , darker chromatin

A- identify
B- describe
A- Chronic inflammation in the synovium from the joint of a patient with rheumatoid arthritis.
B- inflammatory cells They appear as collections of dark blue lymphocytes.

A- identify
B- describe
C- identify the marked structure
A- Acute and chronic inflammation of gastric mucosa.
B- The presence of lymphocytes plus neutrophils , macrophage and plasma cells
C- eosinophilic binucleated

A- identify
B- describe
A- Granulomatous inflammation
B- Showing numerous confluent granulomas in upper
lung fields in a case of active pulmonary tuberculosis

A- identify
B- describe
A- Granulomatous inflammation
B- Presence of scattered granulomas in the parenchyma.

A- identify
B- describe
A- Granulomatous inflammation
B-Tow pulmonary granulomas , Consists of epithelioid cells, giant cells, lymphocytes, plasma cells, and fibroblasts.

A- identify
B- describe
C- identify the marked structure
A- Granulomatous inflammation
B-langhans type giant cells within a Granuloma
Nuclei: Lined up around the periphery of the cell , The rest of the granuloma is mostly composed of pink epithelioid macrophages.
C-langhans type giant cells

A- identify
B- describe
A- Caseating granuloma. (Grossly)
B- the cut surface show’s creamy white area ( granular cheesy appearance ) due to caseous necrosis

A- identify
B- describe
A- typical Tuberculosis Granuloma
B- area of central necrosis surrounded by multiple langhan type giant cells , epithelioid cells , lymphocyte

A- identify
B- describe
C- identify the marked structure
A- Caseating granuloma
B-Central area of necrosis (appears pink, amorphous, and irregular) Surrounded by epithelioid cells.
C- area of Necrosis

A- identify
B- describe
C- identify the marked structure( arrow)
A- Acid fast stain showing mycobacteria.
B- Presence of thin red rod-like organisms (indicated by arrows).
C- Mycobacteria

A- identify
B- describe
C- identify the marked structure
A- Granulation tissue
B- ingrowth of capillaries filled with RBCs accompanied with fibroblast producing collagen aids in healing of inflammation
C- active fibroblast

A- identify
B- describe
A- Granulation tissue ( healing skin wound )
B- skin surface re-epithelialized , below it there is granulation tissue with capillaries and fibroblast producing collagen . After a month there will be small collagenous scar remain

A- identify
B- describe
A- Keloid scar
B- Raised modular mass , smooth to rubbery and firm

A- identify
B- describe
A- keloid scar
B- lesion of deep dermis , sparing papillary dermis
Showed characteristic of long , broad closely backed collagen bundles that stain uniformly eosinophilic ( keloids collagen ) arranged in haphazard fascicles

A- Identify the object
B- Precautions for collection
A -Stool collection container
B- • Must be a clear container with no contamination (urine or water).
• If the sample is liquid, it must be examined within 30 minutes.
• If it's formed, there is no strict time limit
it should be kept at 4°C.
• Preservatives used if examination is delayed: Formalin solution or polyvinyl alcohol (PVA ) fixative or merthiolte iodine formalin ( MIF)

A- Identify
B- what is the methods of diagnosis , or we see it in what specimen ?
C - in macroscopic examination we look at
A- Adult Ascaris (Roundworms).
B- Examination of ( Feces )
C- Consistency , Colour , Odour , presence of blood , mucous or pus like in amoebic dysentery

A- what is the method of examination used here
B-identify the technique
C- Identify A&B in the picture and used for what
D- explain the procedure
A- examination of feces
B- wet mount preparation
C- (A) iodine wet mount , used for identification of protozoan cyst , (B) wet mount saline , used for identification of protozoal cyst , larvae and ova
D-
Saline and iodine are used in the preparation of wet mounts on glass slides.
A drop of normal saline (0.9%) is put at one end and an iodine drop in the another end.
A minute portion of feces is added to both drops.
Mixed with a wooden stick to make a uniform suspension.
cover slip is placed over suspension gently to avoid bubbles.
Examine the preparation under low power objective lens of microscope.

A- what is the method of examination used here
B-identify the technique
C- Identify A,B,C,D in the picture
D- Used for what
E- Which layer contains the parasites for examination?
F-Why can't this methods be used to detect Trophozoites?
A- examination of feces
B- Concentration methods ( Sedimentation or ether formaldehyde technique )
C- (A) ether layer (B) ether - fecal layer (C) formalin layer (D) sediment ( stool ) layer
D-When the parasite is scanty (low number) in feces, used to selectively concentrate eggs, larvae, and cysts.
E- sediment layer ( D)
F-Because Trophozoites are destroyed by the concentration methods.

A- what is the method of examination used here
B-identify the technique
C- Used for what
D- Why can't concentration methods be used to detect Trophozoites?
E- Give another example of the same technique
A- examination of feces
B- Concentration methods ( Floatation technique)
C- When the parasite is scanty (low number) in feces, used to selectively concentrate eggs, larvae, and cysts.
D-Because Trophozoites are destroyed by the concentration methods.
E- Sedimentation technique
A- what is the method of examination used here
B-identify the used technique
C- how to use it
D- what is the organism
E- what is the stain
A- blood examination
B- wet preparation
C-
Place a drop of anticoagulated blood on a clean glass slide.
Put a cover slip over the blood drop.
Search for the motility of parasites like trypanosomes and microfilariae under the microscope.
D- trypanosomes
E- Giemsa stain

A- what is the method of examination used here
B-identify the used technique
C- how to use it
D- what is the organism
A- blood examination
B- wet preparation
C-
Place a drop of anticoagulated blood on a clean glass slide.
Put a cover slip over the blood drop.
Search for the motility of parasites like trypanosomes and microfilariae under the microscope.
D- Microfilariae

A- what is the method of examination used here
B-identify the used technique
C- identified 1,2,3,4,5,6
A- blood examination
B- stained blood smears
C -
thin smear
thick smear
thin smear
Thin smear
Thick smear
Thick smear

A- what is the method of examination used here
B-how to use it
C- What is the name of organism in (A)
D- what is the difference between (B) and (C)
E- what is the name of the stain
A- urine examination
B- Drop of urine sediment is placed on glass slide , cover slip is placed over it and examined under microscope
C- wuchereria bancrofti
D- in ( B ) urine without Chyluria , in (C) urine with chyluria
E- methylene blue stain

A- what is the method of examination used here
B-how to use it
C- What is the name of organism
A- urine examination
B- Drop of urine sediment is placed on glass slide , cover slip is placed over it and examined under microscope
C- Schistosomsa haematobium egg

A- what is the method of examination used here
B-how to use it
C- What is the name of organism
A- urine examination
B- Drop of urine sediment is placed on glass slide , cover slip is placed over it and examined under microscope
C- Trichomonas vaginalis

A- what is the method of examination used here
B-how to use it
C- What is the name of organism in
A- examination of sputum
B-Mix the sputum specimen with an equal volume of 3% NaOH or 5% KOH solution ( This step is done to make the specimen liquid )
• Centrifuge the mixture to separate the components.
• Decant the supernatant and examine the deposit under the microscope to look for eggs and larvae.
C- paragonimus westermani

A- what is the method of examination used here
B-What is the name of organism in
C- found from what aspirate
A- examination of aspirate
B-trophozoites of giradia lamblia
C- from duodenal aspirate

A- what is the method of examination used here
B-identified the number from 1 to 6
C- what organism can found in this method
A- examination of biopsy
B -
Needle biopsies
Surgical biopsy
Endoscopic biopsy
Punch biopsy
Bone marrow biopsy
Liquid biopsy
C- Trichinosis , onchocerciasis

A- what is the method of examination used here
B- Identified the method in the picture
C- what is importance
D- what organism can found in this method
E- give other examples of same method
A- serological examination
B- ELISA
C- (Antigen Detection): is more important than antibody detection because it represents acute recent infection, indicating a need for treatment and prognosis.
D- leishmania , toxoplasmosis , amoebiasis
E - IHA , FAT

A- what is the method of examination used here
B- what is the name of this medium
C- what is its components
D- what organism can found in this media
E- what is importance
A- Culture examination
B- Diamond medium.(Liquid or semi-solid culture medium).
C- Complex nutrients (trypcase and yeast), energy source (carbohydrate), buffering system (phosphate), serum supplement (bovine serum), and iron source.
D- Entamoeba histolytica and Trichomonas vaginalis.
E- increase number of parasites for diagnosis

A- what is the method of examination used here
B- what is the name of this medium
C- what is its components
D- what organism can found in this media
E- what is importance
A- Culture examination
B- Novy mackneal Nicolle medium.(Biphasic culture medium).
C- * Solid part: Blood agar. Liquid part: Locke’s solution (NaCl, KCl, CaCl , phosphatase, glucose).
D- Leishmania and Trypanosoma.
E- increase the number of parasites for diagnosis

A- what is the method of examination used here
B- what is the name of this medium
C- what is its components
D- what organism can found in this media
E- what is importance
G- it’s resemble to what media ?
A- Culture examination
B- Robinson’s medium. ( Xenic cultivation - biphasic culture medium)
C- Egg, nutrient broth, starch, phosphate buffer (pH 6.8-7), and bacteria flora (E. coli).
D- Entamoeba histolytica
E- increase the number of parasites for diagnosis.
G- Tyron’s media ( for giradia lamblia )

A- what is the method of examination used here
B- what is the organisms can found by this method
C- Define the following animal inoculation abbreviations: IC, IN, PO, OC, FP, IP, IM, IV, and SC.
A- Animal Inoculation.
B-
Toxoplasmosis (in mice).
• Leishmania donovani (in hamsters).
• Trypanosoma spp (in mice).
C- • IC: Intracerebral inoculation.
• IN: Intranasal inoculation.
• PO: Peroral inoculation.
• OC: Ocular inoculation.
• FP: Footpad inoculation.
• IP: Intraperitoneal inoculation.
• IM: Intramuscular inoculation.
• IV: Intravenous inoculation.
• SC: Subcutaneous inoculation.

A- what is the method of examination used here
B-identify the used technique
C- what is the type of this technique in this picture
D - how to use it
E- what its importance
A- blood examination
B- stained blood smears
C - Thick blood Smear
D- • Step 1: Place 4 drops of blood in the middle of a glass slide.
• Step 2: Use the corner of another slide to mix the drops together.
• Step 3: Spread the blood to form a square area of approximately 1 cm x 1 cm.
• Step 4: The smear must be dehaemoglobinized prior to staining with Giemsa stain.
E- It’s highly sensitive to detect parasites
A- what is the method of examination used here
B-identify the used technique
C- what is the type of this technique in this picture
D - how to use it
E- what its importance
A- blood examination
B- stained blood smears
C - Thin blood smear
D-Step 1: Place a drop of blood at one end of a clean glass slide.
• Step 2: Use another glass slide (spreader) at an angle of 30 degrees.
• Step 3: Push the spreader gently to the other end of the slide to create a single layer of red blood cells.
E- it’s less sensitive so it is shows extracellular and intracellular the parasite species because it shows clear morphology of the RBCs.

A- identify
B- features / give a comment
A- White Adipose connective tissue
B-Cell: Unilocular Adipocyte that are rounded or oval cells
Nucleus: flat and peripheral
Cytoplasm:Thin rim , one large fat droplet ,(signet ring appearance) , less blood capillary surround it , separated by Loose CT
Type of stain : stains orange in Sudan III
EM: few Mitochondria , SER around the nucleus
Site : Subcutaneous tissue , Perinephric fat
Function:Storage fat , support organs , Heat insulator